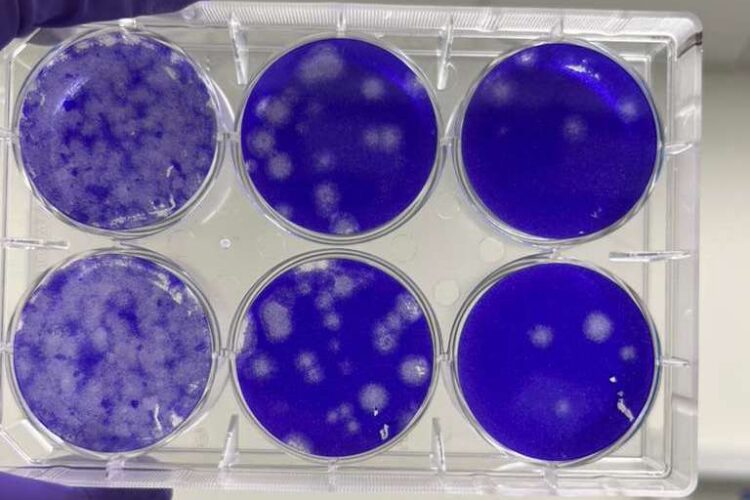
WhatsApp Image 2025-12-26 at 5.36.09 PM (6)

Innovate. Synthesize. Impact.
ARNAV BIOTECH
ARNAV BIOTECH
High-Quality mRNA Design, Synthesis & Support — Globally
Empowering scientists with advanced mRNA technologies, from custom design to high-quality synthesis and expert support.
ARNAV BIOTECH
Our Premium Services
We offer mRNA design services and collaboration options to help you!

ARNAV BIOTECH
End-to-end mRNA solutions designed to accelerate innovation and impact.
A trusted global partner delivering high-quality mRNA solutions that enable breakthrough science and real-world impact.
Research
Products
Service
- Vaccines
- Nebulized Therapeutics
- Precision RNA Therapeutics
- Infectious Diseases
- Oncology
- Biodefense
- DECORATOR™ mRNA
- Functional mRNA
- Reporter mRNA
- Basic Pathology Testing
- Custom Synthesis
- mRNA Design
- Custom Conjugation
- Collaborate





Our scale and reach to client Satisfaction
70
%
Number
COST-EFFECTIVE
70
+
Number
ACCURACY
70
+
Number
SATISFACTION
70
%
Number
FASTER
Our Products
mRNA
- Reporter mRNA: GFP, FLuc, Epo, SEAP (Alkaline phosphatase), beta galactosidase,
- Immunogenic mRNA: Ova, SARS-CoV-2 spike protein
- Gene editing: Cre, Cas9, Lbu Cas13
- LNP screening reporter mRNA: Decorator
Trusted by